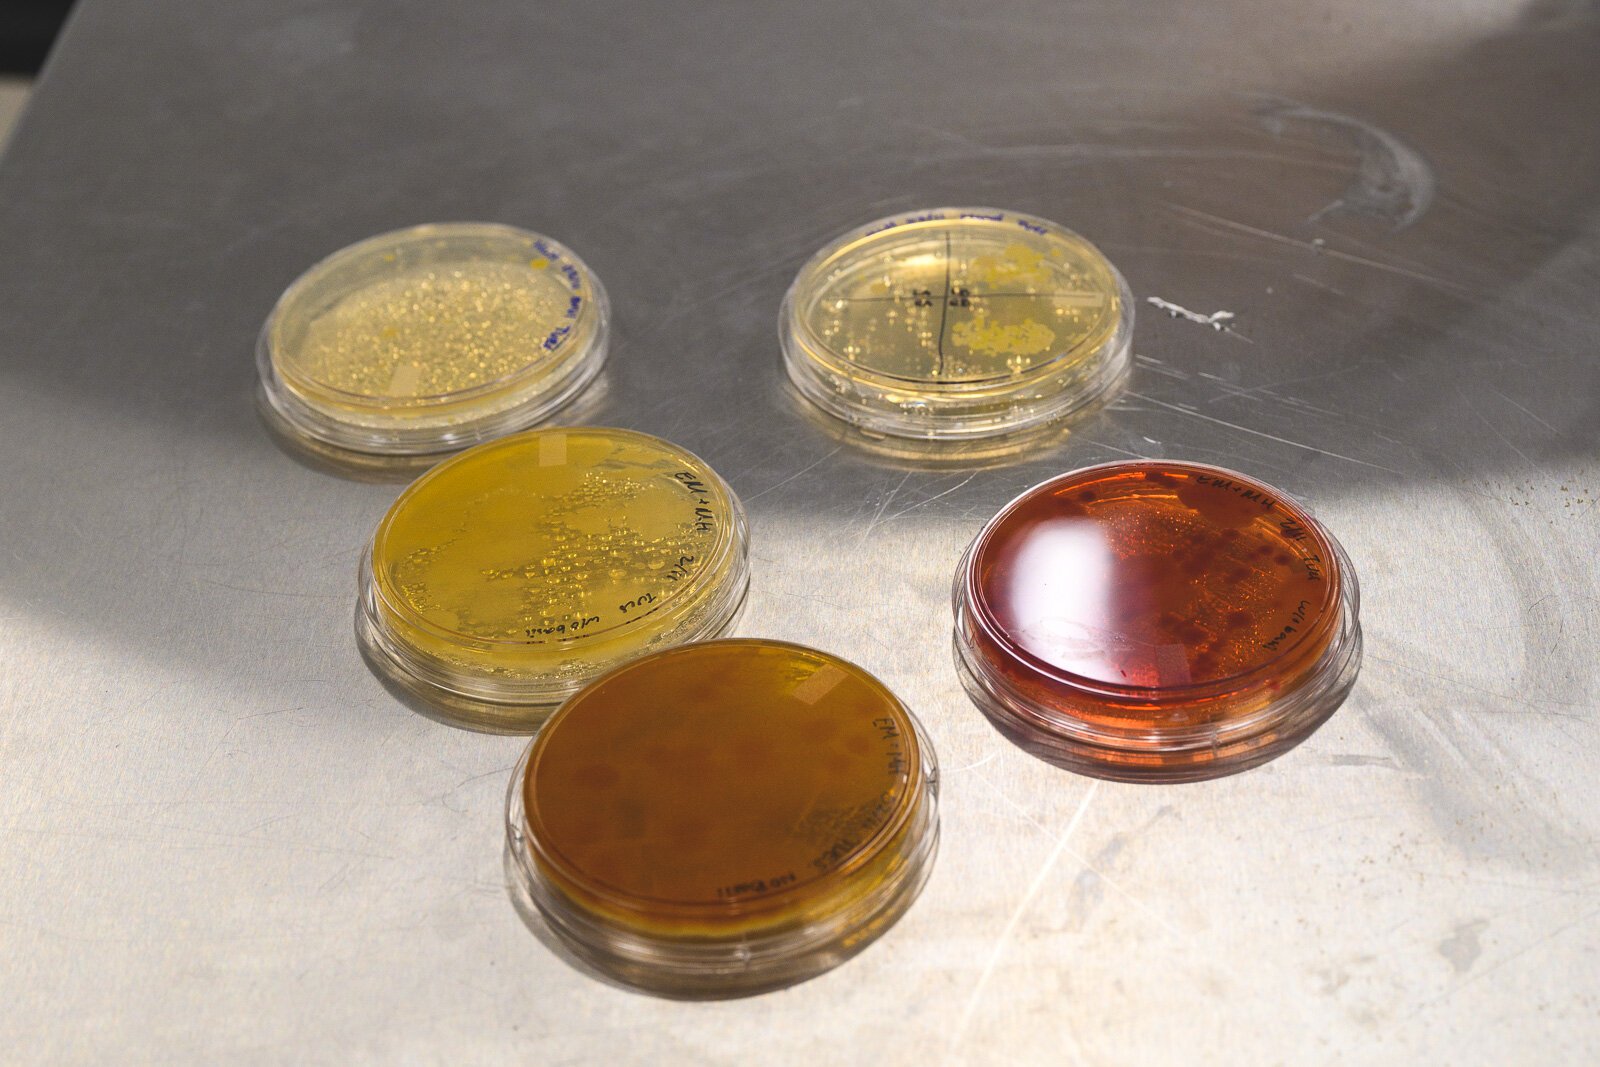

With a strong emphasis on translatable skills and real-world application, EMU’s program has become a standout in fermentation education.
More than just a homebrewing class, Eastern Michigan University’s (EMU) Fermentation Science program is a hands-on, science-driven bachelor’s degree program designed to prepare students for a wide range of careers in fermentation, food science, and beyond. With a strong emphasis on student versatility and real-world application, EMU’s program has become a standout in fermentation education.
“The throughline of the program from the beginning is a focus on the translatable skills,” says Dr. Cory Emal, EMU organic chemistry professor and lead coordinator for the program. “The program gives students a lot of basic science and lab courses that are broadly translatable outside of fermentation, because we want our students to have really broad job prospects after graduation.”
The program got its start in 2016, when Emal says there was “a boom in the field of craft beer brewing.” But he says he wanted to ensure that course material would still be relevant to students once that boom inevitably reached a “plateau.” He also wanted the program to feel accessible to all students, regardless if they had any experience in homebrewing or not.
“Not a large number of students have had any experience brewing on their own,” Emal says. “That’s really what’s heartening from the teaching side of things. No one is taking this class because it’s required for medical school. They’re in the class because they are interested in the subject matter.”

EMU fermentation instructor Taylor Heckaman at EMU’s fermentation lab.
One former EMU fermentation science student, Taylor Heckaman, originally started studying dentistry at EMU. During his junior year, he’d fulfilled his pre-dental requirements but needed three more credits to stay on track. He says that opened up opportunities for him to take “fun” and “interesting” classes that didn’t necessarily apply to his career path, which ultimately led him to fermentation science.
“As an upper-level science student, a science course focused on food and beverages seemed like a no-brainer choice,” Heckaman says. “I was drawn to the course out of a curiosity in the subject matter and a need to fill credits, but I didn’t know how this course would change the future of my career.”
David Wolf dual-majored in fermentation science alongside his cell and molecular biology major at EMU. He got interested in fermentation in 2016 when his brother’s friend introduced him to his homebrewing setup in his garage. Wolf says he was immediately fascinated by the process, and while his first attempts at brewing his own beer were “far from refined,” he taught himself more about the process before making his way into Emal’s classroom.

Taylor Heckaman’s Introduction to Fermentation Science Laboratory class at Eastern Michigan University.
“I quickly immersed myself in all-grain brewing and developed a deep appreciation for the science behind it,” Wolf says. “The hands-on exploration solidified my passion for fermentation science and set me on a path toward formal education and a professional career in the field.”
EMU students can pursue fermentation science as a major, or as a minor alongside biology, biochemistry, or chemistry majors. The course is housed in the university’s Mark Jefferson building, which received two remodels over the course of 10 years to craft tailored spaces for both fermentation science as well as EMU’s neuroscience program.
“Students in advanced courses can get hands-on experience with a small but still commercial-sized setup,” Emal says. “Having these purpose-built spaces where we can do hands-on work has really positioned the program to do more things that help contextualize the work a lot more for the students.”
Students find successful brewing careers
Both Wolf and Heckaman have since taken the skills they learned from the program into the brewing and hospitality fields. Heckaman is now head brewer for Ypsi Alehouse, and Wolf is brewing at Brewery Becker in Brighton. Heckaman has also returned to the fermentation science program as an instructor. Their journeys highlight the program’s impact not just in launching careers, but in fostering a cycle of mentorship and industry growth.
“Working at the Alehouse has been an incredibly important and useful experience because of the networking, the skills I’ve gained, and the experiences I can bring to the students and the program,” Heckaman says. “Without this program, I likely wouldn’t have learned the skills necessary to brew beer, and I wouldn’t be teaching the same things to my students now.”
“My experience in the program was transformative, providing both technical knowledge and valuable industry insights,” Wolf says. “The combination of theoretical coursework, hands-on lab work, and collaborative projects equipped me with a comprehensive approach to fermentation science as a whole.”

Dr. Cory Emal and Taylor Heckaman at EMU’s fermentation lab.
Heckaman credits his success in the brewing industry and the classroom to Emal.
“Dr. Emal has most certainly helped me build the knowledge and skills I have today, and without him leading the way this program would not be where it is,” Heckaman says. “This journey has come full circle for me because I am now directly involved in teaching many of the courses, as well as working closely with Dr. Emal to continue building the program. We make a great team.”
Award-winning brews
Many of Emal’s students have showcased their brewing skills in competition at the U.S. Open College Beer Championship, the “only competition of its kind focusing on student brewers,” according to the championship’s website. Students split into teams based on the kinds of brews they want to make, and Emal utilizes his skills as a certified beer judge to help students craft their final products.
“We’ve been entering the championship since 2021, when we came in seventh overall,” Emal says. “In 2022, we came in fourth, then in second in 2023. I showed my students in last year’s class the trend and joked we only had one more spot to go.”
Joke aside, EMU was named Grand National Champion of the U.S. Open College Beer Championship, with three of EMU’s four submitted beers receiving gold medals. Wolf participated in the competition in both 2022 and 2023, helping to secure gold and silver medals for EMU. He says the experience validated his and his classmates’ work, but also provided them with an opportunity to network with other fermentation students and specialists.

Taylor Heckaman’s Introduction to Fermentation Science Laboratory class at Eastern Michigan University.
“These experiences not only reinforced my technical skills, but also allowed me to engage with industry professionals and gain recognition for my work,” Wolf says.
Emal hopes that the program prepares students for a variety of career options, while still being accessible to those students who may not enter a science field at all after graduation. He says he wants students to gain useful skills for whatever field they choose to enter.
“In all the courses I teach, my role here is to get students to the next step,” Emal says. “I’m not trying to form anyone in any particular image. I’m trying to give them the tools they need to do their own thing.”
Rylee Barnsdale is a Michigan native and longtime Washtenaw County resident. She wants to use her journalistic experience from her time at Eastern Michigan University writing for the Eastern Echo to tell the stories of Washtenaw County residents that need to be heard.
Photos by Doug Coombe.